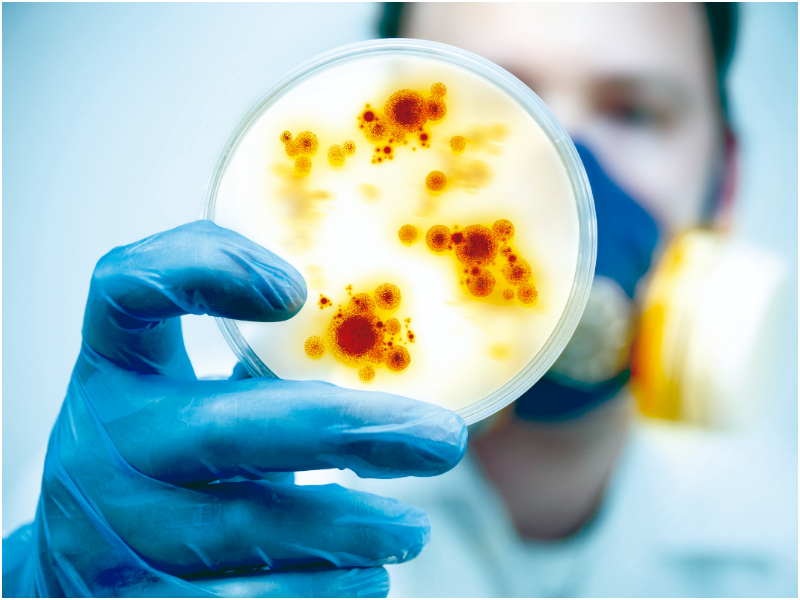
bacteria

La directora de Epidemiología del Ministerio de Salud (Minsa) en Chiriquí, Erika
Ferguson, informó este miércoles la muerte de un bebé que se mantenía en la
sala de aislamiento del Materno Infantil José de Obaldía después de ser colonizado por una bacteria multirresistente.
MÁS NOTICIAS: Investigan la muerte de bebé de un año y dos meses en Bocas del Toro
El lactante tenía comprometida su salud por otros diagnósticos clínicos y falleció el pasado lunes en el centro médico, precisó la funcionaria del Minsa.
Ferguson adelantó que aún permanecen en la sala de aislamiento, que fue especialmente habilitada para esta contención de la bacteria, otros seis pacientes, tres de ellos colonizados.
Las autoridades médicas del Materno Infantil José de Obaldía detectaron a medidados de febrero esta bacteria multirresistente en la sala de cuidados críticos del Hospital, procediendo de inmediato a aplicar medidas de contingencia y de bioseguridad.
El primer caso se trató de un lactante que había esto siendo tratado en varios hospitales en Bocas del Toro y la ciudad de Panamá y que llegó al Materno Infantil con la bacteria.
El menor fue dado de alta, pero luego se descubrió que otros dos pacientes de la sala habían sido colonizados y se les siguió dando la atención en una sala de aislamiento
que fue habilitada.
Fuente: TVN-2